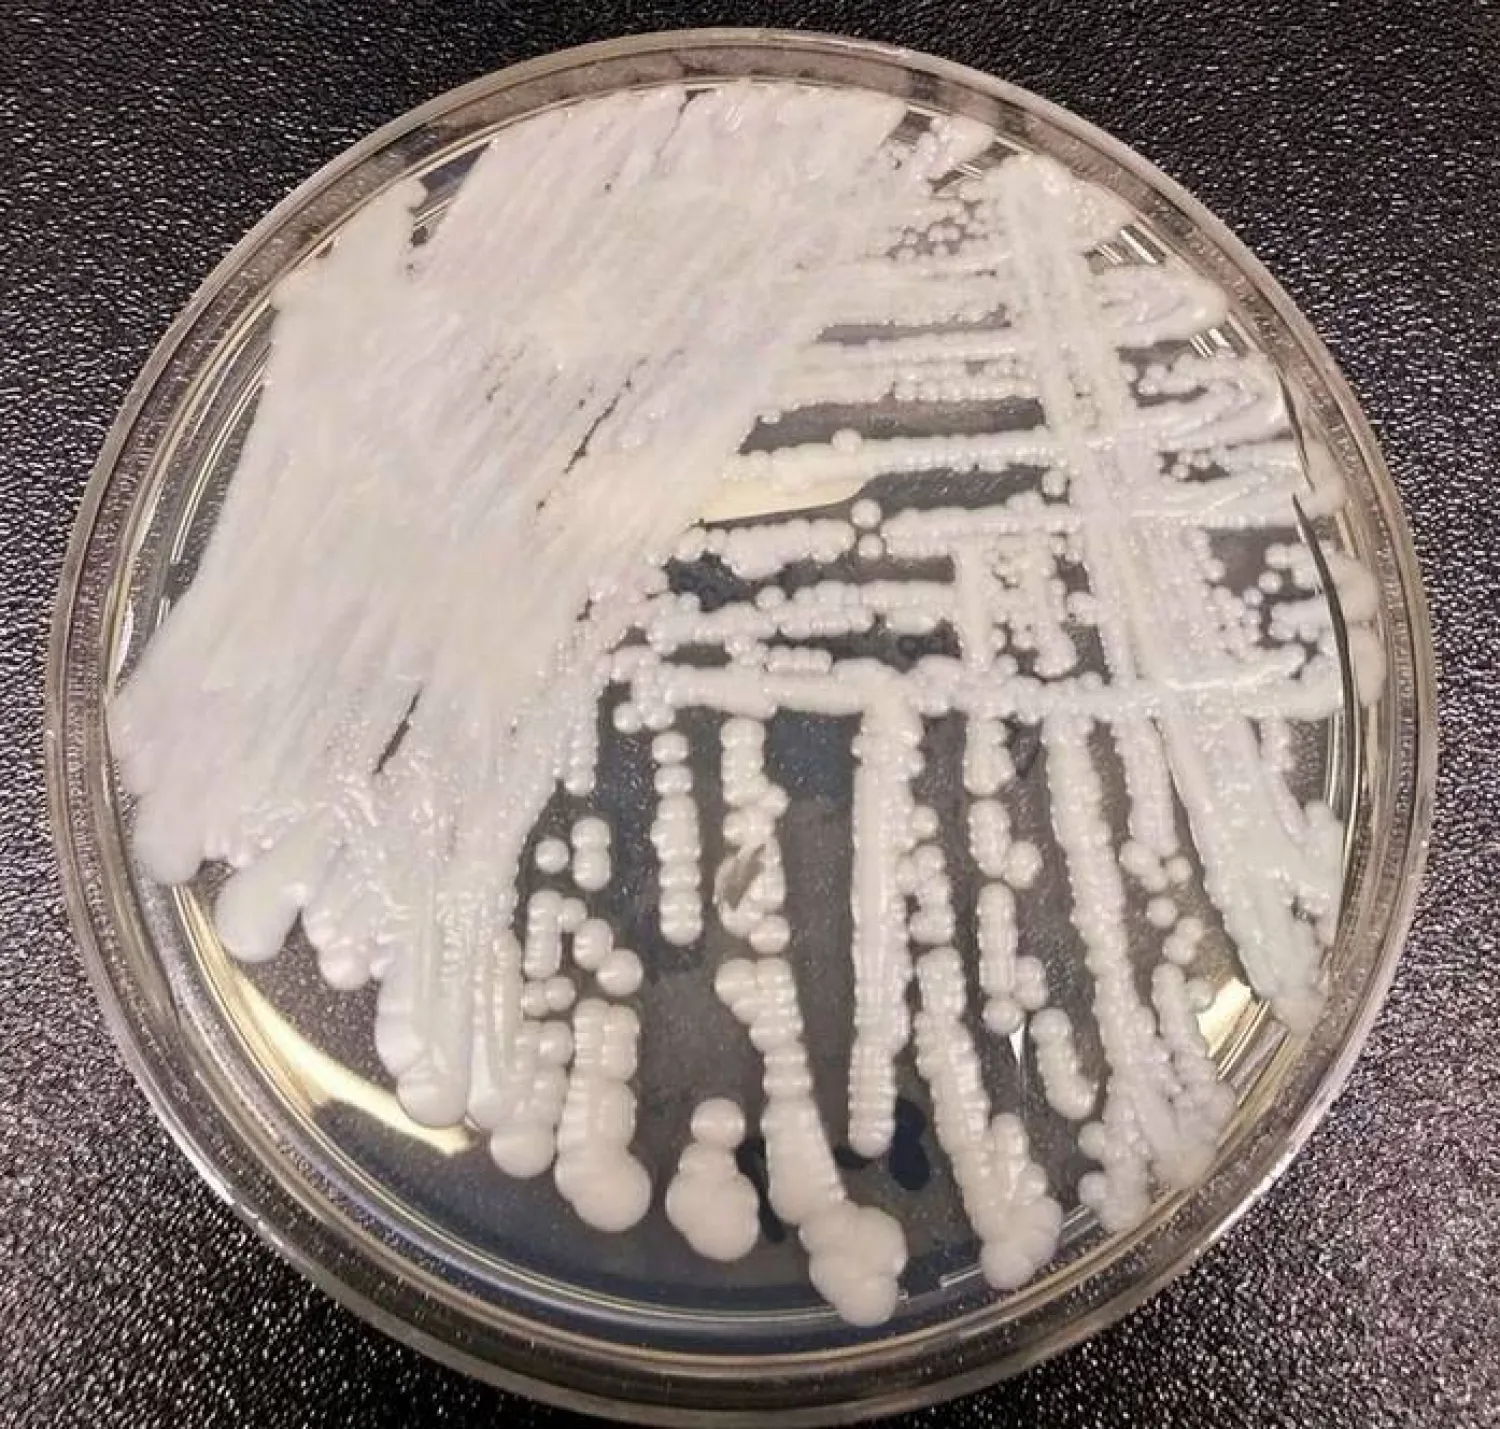
طبيب يكشف الفرق بين العدوى الفطرية البسيطة والخطيرة

كشف طبيب الأمراض الجلدية الهندي الدكتور أس كي غوبتا، أن المراحل المختلفة للعدوى الفطرية ضرورية للكشف المبكر والتشخيص الدقيق والعلاج الفوري، وذلك وفق تقرير جديد نشره موقع «onlymyhealth» الطبي المتخصص.
إذ ان الالتهابات الفطرية أمر شائع يمكن أن يصيب أجزاء مختلفة من الجسم، بما في ذلك الجلد والأظافر والأغشية المخاطية.
العدوى الأولية
تحدث المرحلة الأولى من العدوى الفطرية عندما يدخل الكائن الفطري إلى الجسم. يمكن أن يحدث هذا من خلال الاتصال المباشر مع الأسطح الملوثة أو استنشاق الأبواغ الفطرية أو حواجز الجلد المعرضة للخطر.
في البداية، قد تظهر العدوى على شكل بقعة حمراء صغيرة أو طفح جلدي أو حكة موضعية. وفي بعض الحالات، قد تكون المنطقة المصابة مصحوبة بالتهاب طفيف أو تورم. ومن المهم تحديد هذه العلامات المبكرة وطلب العناية الطبية لمنع العدوى من التقدم أكثر والانتشار إذا تركت دون علاج؛ حيث يمكن أن تتطور العدوى الفطرية إلى المرحلة الثانية؛ ويبدأ الفطر عندها بالتكاثر والانتشار.
المرحلة الثانية
في هذه المرحلة، قد تصبح العدوى أكثر وضوحًا وتظهر أعراضًا مميزة.
يمكن أن تختلف هذه الأعراض حسب نوع العدوى الفطرية والمنطقة المصابة من الجسم.
وتشمل العلامات الشائعة زيادة الاحمرار والحكة والحرقان وتشكيل بثور أو بثور وتقشير أو تقشر الجلد. وفي بعض الحالات، قد تمتد العدوى إلى المناطق المجاورة، ما يؤدي إلى تكوين مجموعات أو بقع من الجلد أو الأظافر المصابة.
العدوى المزمنة أو المتكررة
في حالات معينة، قد تدخل العدوى الفطرية مرحلة مزمنة أو متكررة. يمكن أن يحدث هذا بسبب عوامل مختلفة مثل العلاج غير الكافي أو الظروف الصحية الأساسية أو ضعف جهاز المناعة أو التعرض المتكرر للفطر.
ووفقًا لبحث؛ غالبًا ما تظهر الالتهابات الفطرية المزمنة بأعراض مستمرة وميل للتكرار حتى بعد العلاج. فقد تظهر على المنطقة المصابة علامات التهاب مطول وحكة مستمرة وسماكة أو تغير لون الجلد أو الأظافر وتشكيل تشققات. وقد يتطلب علاج الالتهابات المزمنة أو المتكررة نهجًا أكثر شمولاً واستهدافًا، بما في ذلك العلاج المضاد للفطريات لفترات طويلة ومعالجة أي مشكلات صحية أساسية.
العدوى الفطرية الخطيرة
في الحالات الشديدة أو عندما يكون الجهاز المناعي ضعيفًا بشكل كبير، يمكن أن تتطور العدوى الفطرية إلى المرحلة الرابعة، حيث تنتشر العدوى إلى أجزاء أخرى من الجسم. يُعرف هذا بالعدوى الفطرية المنتشرة أو الجهازية، ويمكن أن يشكل مخاطر صحية كبيرة.
وقد تشمل الأعراض الحمى والتعب وفقدان الوزن وأعراض خاصة بالأعضاء (مثل إصابة الرئة أو مجرى الدم) والآفات الجلدية التي تمتد إلى ما بعد الموقع الأساسي للعدوى.
وتعد الالتهابات الفطرية الجهازية من حالات الطوارئ الطبية وتتطلب عناية طبية فورية للتشخيص والعلاج المناسبين.
مناهج العلاج
عادةً ما يتضمن علاج الالتهابات الفطرية الأدوية المضادة للفطريات، سواء أكانت موضعية أم جهازية اعتمادًا على شدة العدوى وموقعها.
وبالإضافة إلى الأدوية، قد يوصى بتدابير أخرى مثل الحفاظ على المنطقة المصابة نظيفة وجافة وارتداء أقمشة قابلة للتنفس وممارسة النظافة الجيدة وتجنب العوامل التي تعزز نمو الفطريات (على سبيل المثال الرطوبة الزائدة أو الأحذية الضيقة).
وفي هذا الاطار، بحالات العدوى المزمنة أو الجهازية، قد يكون من الضروري اتباع نهج متعدد التخصصات يشمل أخصائيي الرعاية الصحية المتخصصين في الأمراض الجلدية أو الأمراض المعدية أو علم المناعة.
الوقاية من الالتهابات الفطرية
للوقاية ن الالتهابات الفطريات ومنع هذه العدوى يجب اتباع الأمور التالية:
- ممارسة النظافة الجيدة
- الحفاظ على الجلد جافًا ونظيفًا
- تجنب مشاركة الأغراض الشخصية
- ارتداء الأحذية المناسبة في الأماكن العامة
- الحفاظ على نظام مناعة صحي من خلال نظام غذائي متوازن وممارسة التمارين الرياضية بانتظام والراحة الكافية.
يمكن أن يساهم العلاج الفوري لأي ظروف صحية أساسية ومعالجة عوامل الخطر في الوقاية من الالتهابات الفطرية.